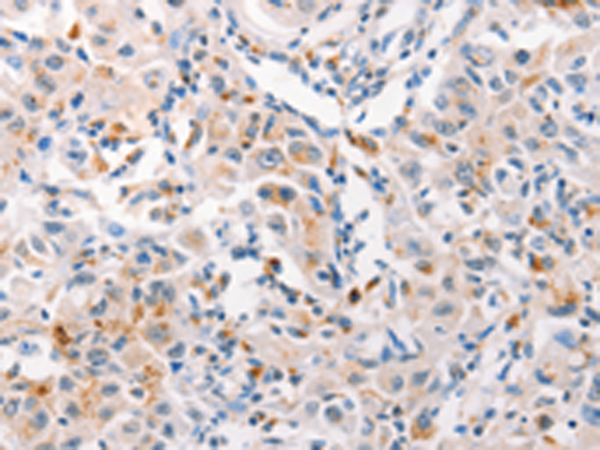

别名:MLP, SMUC, MUC-2应用:IHC
反应种属:Human
规格:50μl/100μl
| Description |
|---|
| This gene encodes a member of the mucin protein family. Mucins are high molecular weight glycoproteins produced by many epithelial tissues. The protein encoded by this gene is secreted and forms an insoluble mucous barrier that protects the gut lumen. The protein polymerizes into a gel of which 80% is composed of oligosaccharide side chains by weight. The protein features a central domain containing tandem repeats rich in threonine and proline that varies between 50 and 115 copies in different individuals. Alternatively spliced transcript variants of this gene have been described, but their full-length nature is not known. |
| Specification | |
|---|---|
| Aliases | MLP, SMUC, MUC-2 |
| Swissprot | Q02817 |
| Host/Isotype | Rabbit IgG |
| Storage | Store at 4°C short term. Aliquot and store at -20°C long term. Avoid freeze/thaw cycles. |
| Species Reactivity | Human |
| Immunogen | Synthetic peptide of human MUC2 |
| Formulation | pH7.4 PBS, 0.05% NaN3, 40% Glycerol |
| Application | |
|---|---|
| IHC | 1/50-1/200 |
| ELISA | 1/2000-1/5000 |
 |
The image is immunohistochemistry of paraffin-embedded Human lung cancer tissue using P04359(MUC2 Antibody) at dilution 1/60. (Original magnification: ×200) |
|
The image is immunohistochemistry of paraffin-embedded Human liver cancer tissue using P04359(MUC2 Antibody) at dilution 1/60. (Original magnification: ×200) |
本公司的所有产品仅用于科学研究或者工业应用等非医疗目的,不可用于人类或动物的临床诊断或治疗,非药用,非食用。
暂无评论
本公司的所有产品仅用于科学研究或者工业应用等非医疗目的,不可用于人类或动物的临床诊断或治疗,非药用,非食用。
 中文
中文 








发表回复